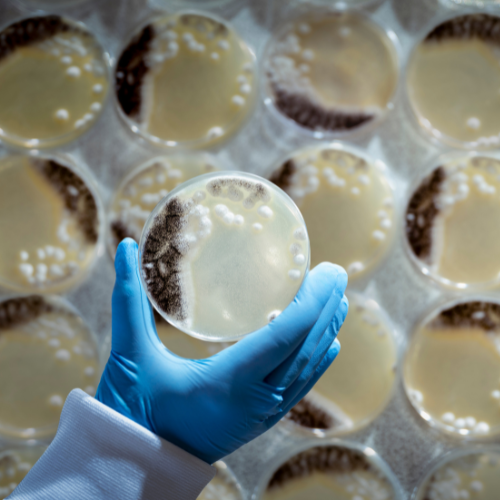

Contract Microbiology Services
Microbiology Laboratory
Our microbiology laboratories, which began operation in the late 1980s, have been offering contract research and sample analysis since 1991 and have been GLP compliant since 1994. The type of work that we can accommodate encompasses the whole spectrum of microbiology, from routine analysis/quality control to substantial research and development programmes for major multinational pharmaceutical companies.
In addition to our membership of the UK GLP compliance program, we comply with national and international standards as required, including BS / EN / ISO / ASTM test methods, BSAC, EUCAST and CLSI guidelines.
Veterinary
Mycoplasma Testing
MIC Testing
MIC Testing
Testing
![]()
Assays
![]()
Enumeration of
Biotherapeutics
Antifungal
Susceptibility Testing
Compliance
Counts Scheme
For further information on how we can support your microbiology needs:
Read our brochure
or email us sales@dwscientific.co.uk
or call us +44 (0)1274 595728
Mycoplasma Testing
The microbiologists at DWS have extensive knowledge and expertise in mycoplasma testing. We are particularly skilled in antibiotic susceptibility testing of mycoplasma species of animal origin. After years of isolating mycoplasmas from cattle, swine, and poultry samples, we have assembled a substantial collection of veterinary mycoplasma species, including M. hyopneumoniae, M. hyorhinis, M. gallisepticum, M. synoviae and M. bovis.
We use species-specific optimized broth microdilution methods to determine the Minimal Inhibitory Concentration (MIC) of antimicrobial agents against mycoplasmas. Through our ongoing collaborations with several European pharmaceutical companies, we monitor antibiotic susceptibility within the various species of veterinary significance. There are currently no standardised documents for mycoplasma MIC testing, but working with us will allow you access to standardized, reproducible methodology developed at DWS and based on CLSI guidelines.
Click here to view one of our recent publications on mycoplasmas.


Aerobic MIC Testing
At DWS, the Minimal Inhibitory Concentration (MIC) of an antimicrobial agent against aerobes is usually determined by the broth microdilution method, which provides both quantitative and qualitative interpretation of results.
Antibiotic concentrations typically tested are 128 to 0.008 µg/ml, but with advice from the customer, manufacturer or supplier of the test substance, this range may be modified. Test strains can be supplied by the customer or can be chosen from our extensive culture collection. Appropriate Quality Control strains are included in every set of MIC tests.
The MIC is recorded as the lowest concentration of test substance that inhibits growth. To finalise each study, we prepare a report of all methodology and results, which are summarized in a tabular format showing the MIC50, MIC90 and Geometric Mean MIC values.
The MIC50 is the minimum concentration of test compound inhibitory to 50% of the test strains in a particular group. The MIC90 is the minimum concentration of test compound inhibitory to 90% of the test strains in a particular group. Geometric Mean MIC is the most appropriate mean for application to data on a logarithmic scale (MIC data are on a log2 scale). |
Anaerobic Agar MIC Testing
The agar dilution technique (standardized by CLSI) is routinely used at DWS to determine the Minimum Inhibitory Concentration (MIC) of antimicrobial agents against anaerobes. Our standard methods for this technique are updated regularly to ensure accuracy and aid compliance with Good Laboratory Practice.
Bacterial strains can be supplied by the customer or can be chosen out of our extensive culture collection. Suitable anaerobic control strains are used in every anaerobic agar MIC test and are dependent on the agar type used.
Using the innovative Whitley Anaerobic Workstations in the DWS laboratory, we can perform culture and MIC testing with the most fastidious anaerobes. All anaerobic agar MIC test plates are typically incubated at 35°C for 42-48 hrs in an atmosphere of 10% CO2, 10% H2 and 80% N2.
The MIC is recorded as the lowest concentration of test substance that completely inhibits growth. To finalise each study, we prepare a report of all methodology and results, which are summarized in a tabular format showing the MIC50, MIC90 and Geometric Mean MIC values.
The MIC50 is the minimum concentration of test compound inhibitory to 50% of the test strains in a particular group. The MIC90 is the minimum concentration of test compound inhibitory to 90% of the test strains in a particular group. Geometric Mean MIC is the most appropriate mean for application to data on a logarithmic scale (MIC data are on a log2 scale). |
Wound Dressing Testing
We have been conducting efficacy testing of antimicrobial wound dressings for several years, comprising agar diffusion tests and log reduction testing in various media, including simulated wound environments.
Laboratory methods used in the evaluation of dressing products include determination of total viable counts by pour plate, surface spread plate and spiral plate techniques. These techniques can also be used in conjunction with shake flask assays.
Organisms required to evaluate wound dressings can be supplied by the laboratory itself as we have vast culture collection containing over 20,000 microorganisms.
Microbiological Assays
We use microbiological assays to measure and compare the potency of antibiotic preparations. Various methods are available for this, some of which are standardized in the pharmacopoeias (BP, EP, USP, Ph Eur). In particular, we are experienced in conducting agar well diffusion assays and have the equipment required to use large assay plates, which improves test throughput.
Biotherapeutics
A live biotherapeutic product (LBP) is a living organism that is prepared and used as a pharmaceutical substance to produce a therapeutic effect. In the DWS laboratory, we work with LBPs comprising live bacteria and fungi, commonly manufactured in lyophilized form. These products are examined by our skilled microbiologists, who are well trained in bacterial and fungal enumeration techniques. Many LBPs are prepared from bacteria that require strict anaerobic conditions and specialized culture media to achieve reliable growth in vitro; we have extensive experience with these requirements and, of course, various anaerobic workstations in which to cultivate fastidious anaerobes.
Quality Control of LBPs in their final dosage form, for example in capsules, is achieved by determining total viable bacterial (or fungal) count using appropriate plate count methods and also by determining total cell count (live and dead cells) by microscopic evaluation in a counting chamber.
Antifungal Susceptibility
A rise in antifungal resistance over the years has seen an increase in test facilities and researchers carrying out antifungal susceptibility testing (AFST).
We use in vitro methodology (broth microdilution or agar dilution, as appropriate) to test the susceptibility of fungi to antifungal products. We can perform antifungal disk diffusion susceptibility testing of yeasts and broth microdilution testing of both yeasts and filamentous fungi such as Aspergillus spp. and Rhizopus arrhizus.
Click here to read a review about MIC testing of antifungals, written by one of our resident microbiologists.

"Quality Counts" Scheme
The DWS Quality Counts scheme is a Proficiency Testing Programme designed specifically for spiral platers, such as the WASP and WASP Touch range. This quality assurance scheme helps to monitor correct operation of a spiral plater (both instrument and operator) and provides valuable assurance of the quality of results obtained from the spiral plate count technique.
Quality Counts participants receive stabilized liquid samples, ready to plate without further preparation, each month. Replicate spiral plates are prepared from the samples and incubated at 37°C. Colony count results are then reported to the DWS Microbiology Laboratory for evaluation. Participants’ results are analysed, and reports are provided to every participating laboratory to indicate whether the submitted plate count falls within the acceptable range, as well as comparing the result with those produced by other participants. In the case of results falling outside the acceptable range, our team of technical experts (microbiologists and service engineers) can offer advice or training to rectify any issues.
Purchase of a WASP or WASP Touch spiral plater in the UK grants access to the Quality Counts Scheme free of charge for the first 12 months. If a laboratory then wishes to continue participation after the first year, this competitively priced programme offers discounts to organisations wishing to include more than one spiral plater within their subscription.
Please contact us for more information.
Please note: This scheme is only available to customers in the UK and Europe.
GLP Compliance
Good Laboratory Practice (GLP) is an internationally recognized quality system for laboratories that covers the organisational process and the conditions under which non-clinical health and environmental studies are planned, performed, monitored, recorded, reported and retained (archived). Compliance with GLP principles helps to ensure the uniformity, consistency, reliability, reproducibility, quality, and integrity of laboratory data. Our microbiology laboratory, has been a member of the United Kingdom Good Laboratory Practice (GLP) compliance programme since 1994.
Our compliance with GLP principles is monitored through regular inspections performed by the UK Medicines and Healthcare Products Regulatory Agency (MHRA).

en


Organism Directory





England